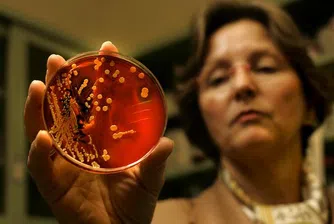
Примитивна бактерия произвежда гориво за ракети

Защо да не напускате старата си работа?
&format=webp)
Когато дълго сте работили на едно място, то най-вероятно сте близо до момента, в който ви се иска промяна и мисълта за нова работата все по-често ви спохожда.
Преди да захвърлите с лека ръка старата такава, обаче помислете за плюсовете и минусите. И докато първите са много по-лесни за откриване, ето някои от минусите за които може и да не си давате сметка.
1. Най-вероятно ще сте на пробен период
Това по своята същност не е лошо, защото дава шанс за двустранно опознаване, на работещия и работодателя. През този период можете да се откажете, ако работата не отговаря на вашите предварителни очаквания, без това да има негативни последствия.
В настоящите условия обаче и на пазар, доминиран от работодателите, много често се злоупотребява с този пробен период. Традиционно през това време условията на работа по отношение на заплащане и на ползване на привилегии от страна на работника са значително по-лоши.
В същото време много работодатели се възползват и злоупотребяват с това, като по икономически съображения непрекъснато освобождават наетите на пробен период след три месеца, и ги заменят с други (особено за длъжности не изискващи специфични умения и квалификация).
В тази насока, ако разчитате на точно определено предложение, за да напуснете сигурното си работно място с предложение за пробен период и то относително по-дълъг помислете отново и имайте и план „Б".
2. Трябва отново да се доказвате
Ако имате извоювани позиции на старата си работа след дългогодишен опит и усилия, не смятайте, че това автоматично ще се прехвърли и на новото ви работно място.
Там ще трябва да започнете да се доказвате от „нула", като ще трябва да мине определен период преди да достигнете определени привилегии и доверие от страна на мениджмънта.
Хората често не си дават сметка за този факт, както и за усилията, необходими им да достигнат до нивото, което вече смятат за минимум за своите възможности.
3. Нови колеги, нови проблеми
Може да ви се струва, че познавате до болка колегите, с които работите и да ви се иска да смените работната среда с „по-добра", но отиването на ново място не го гарантира. Просто ще ви е необходимо време, за да разберете, че новите колеги имат други, или същите „трески за дялане", като старите.
4. Добре е да търсите перспективен сектор
Ако сте решили да сменяте напълно работата си и да се прехвърлите в друг сектор, гледайте това да е развиващ се такъв с добри перспективи. Така ще имате възможност, както за растеж, така и за по-малко конкуренция за работното място, ако отрасълът е в начален стадий на развитие.
Насочването към замиращи сектори може да означава, че ще останете безработни в дългосрочен аспект.
5. Перспективи
Често компаниите привличат, или крадат кадри с обещания за „добри перспективи". Преведено на езика на работещия това може да означава, години на работа при същите или по-лоши финансови условия от достигнатите на старата длъжност.
Също така, трябва да се има предвид каква е политиката на компанията по отношение на повишение на заплатата.
Ако в предишната ви компания тя се е повишавала, примерно, с 10% на година, то ще трябва да работите поне няколко години на новото място, за да знаете какво да очаквате и дали там финансовото стимулиране е сред практиките към персонала и в какви размери.
)
&format=webp)
&format=webp)
&format=webp)
&format=webp)
&format=webp)
&format=webp)
&format=webp)
&format=webp)
&format=webp)
&format=webp)
&format=webp)
&format=webp)
&format=webp)
&format=webp)
&format=webp)
&format=webp)
&format=webp)
,fit(1920:897)&format=webp)
,fit(140:94)&format=webp)
,fit(140:94)&format=webp)
,fit(140:94)&format=webp)
,fit(1920:897)&format=webp)
,fit(140:94)&format=webp)
,fit(140:94)&format=webp)
,fit(140:94)&format=webp)